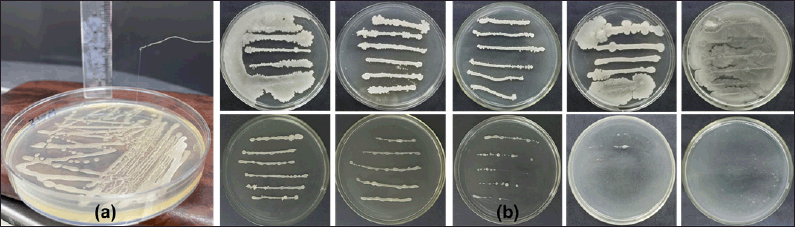
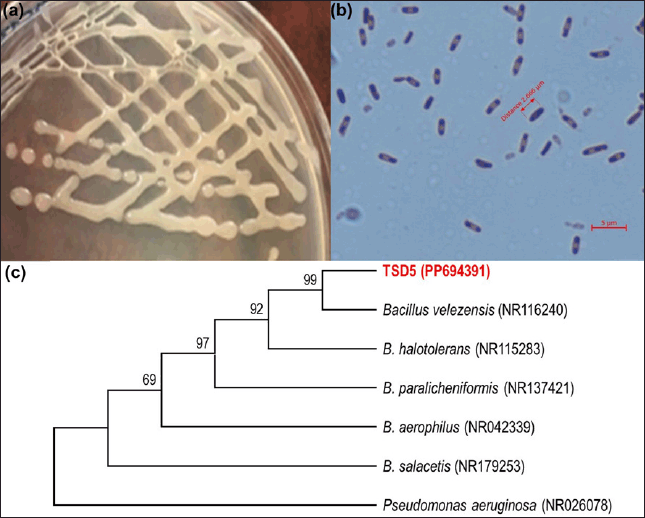

1. INTRODUCTION
Exopolysaccharides (EPS) are natural polymers with many critical biological functions. EPS has been shown to have important properties such as antioxidant [1], cholesterol-lowering [2], antitumor [3], antiviral [4], and immunomodulatory [5] activity. Furthermore, it has been discovered that EPSs improve soil quality and help retain nutrients in the soil, particularly by mitigating environmental factors, which in turn benefits plant health and various abiotic stress situations [6]. When it comes to the production of microbial biofilms, EPS is crucial. Biofilms and interactions between plants and bacteria are essential for several rhizosphere processes, including carbon sequestration and nutrient cycling [7]. A matrix of extracellular EPS surrounds biofilm-secreting bacteria, helping to shield them from antibacterial substances, including antibiotics, UV light, heavy metals, and so on [8]. Additionally, rhizobacteria colonize and establish themselves, thanks in part to these EPS. They can produce EPS to protect themselves and thereby protect plants against adverse environmental conditions. EPS can be produced by plants, algae, fungi, and bacteria.
Because EPS plays an important role in overcoming environmental problems, it has attracted many studies. The addition of EPS-producing bacterial strains has helped reduce soil salinity and improve saline soil [9,10]. EPS-producing bacteria have also shown the ability to protect plants from drought stress by enhancing soil aggregation and increasing soil water retention capacity. Notably, the density of rhizosphere microorganisms that promote plant growth also increased, which plays an important role in improving soil structure [11]. In addition, the applications of heavy metal pollution remediation from EPS-producing microorganisms are also noteworthy. Halomonas sp. produces EPS to help convert As3+ into a less toxic form As6+, helping to biologically restore As-contaminated rice soil [12]. Bacillus sp. produces EPS to help adsorb and reduce the content of heavy metals Cd and Pb, precipitate Fe2Pb(PO4)2, Cd2(PO4)2, and Pb2O3, and increase microaggregates in the root soil. Bacillus sp. added to the soil helps enrich the functional bacterial community in the microaggregates, thereby preventing the adsorption of Cd and Pb by lettuce [13].
Bacillus species are considered significant rhizobacteria that promote plant growth because they produce a wide range of physiologically active secondary metabolites that may prevent the growth of harmful rhizospheric microorganisms and plant diseases [14–16]. Because Bacillus species can develop endospores that withstand heat exposure and desiccation and may be processed into stable, dry powders with extended shelf lives, they are preferred in agricultural systems [17,18]. Exopolysaccharide biopolymers produced by microorganisms are essential for the environment.
The floating islands of the coral archipelago in Khanh Hoa province, Vietnam, have an average height above the water of about 3–5 m with a severe climate. The sun, wind, frequent thunderstorms, lack of fresh water, and numerous island chains devoid of vegetation characterize the archipelago’s extremely harsh environmental and climatic characteristics [19]. Furthermore, because coral sand soil has been replenished by being pulled out from the seabed, it frequently possesses qualities that are detrimental to plant growth, such as being arid, unable to retain water, and rapidly losing nutrients.
EPS-producing Bacillus velezensis strains have shown antioxidant [1], anticancer [3], stimulation of rhizosphere microbial community and plant growth promotion through soil amendment, effective improvement of soil nutrient composition, protection of soil from acidification [20], enhancement of salt tolerance, and increased phosphate uptake by plants [21]. However, studies combining structural analysis with experiments to demonstrate the role of EPS as well as B. velezensis strain in soil are still unclear, especially on dry, saline coral sand soil. This study, through analyzing the properties of EPS to predict some functions of EPS and by experimental application on coral sand soil that needs to be improved to reconfirm the predictions about the water retention, salinity reduction, and soil aggregation of EPS and culture fluid of the EPS-producing B. velezensis TSD5 strain. These findings contribute to clarifying the role and mechanism of EPS as well as the EPS-producing B. velezensis strain in improving dry, saline coral sand soil, thereby opening up many directions for application of this bacterial strain on many different types of soil.
2. MATERIALS AND METHODS
2.1. Coral Soil Samples Collection
Coral soil was collected from an atoll in the coral archipelago of Khanh Hoa province, Vietnam. Culture medium: Lysogeny Broth (LB) (g/l): Pepton 10, Yeast extract 5, NaCl 5, pH 7. LB agar: LB medium supplemented with 15 g/l agar.
2.2. Isolation of a Salt-Tolerant Bacterial Strain Capable of Producing EPS
Weigh 10 g of soil sample and add it to 90 ml of sterile physiological saline. Then, continue diluting from concentration 10-1 to 10-7. Take 150 µl of the dilution and spread it on an LB agar plate supplemented with 3% NaCl, then incubate at 30°C for 72 hours. Shiny colonies with smooth and slimy surfaces will then be selected and checked using the String test method. EPS-producing colonies will produce mucus; the oozing mucus can be seen with the naked eye [22] or use the circular end of the implant to stretch the colony out, elongating into fibers >5 mm is considered positive, capable of producing EPS [23].
Testing the salt tolerance of bacteria: The salt tolerance of the bacterial strain was conducted based on [24,25]. The selected bacterial strain was cultured in LB agar medium supplemented with 0%–20% NaCl and incubated at 30°C for 46 hours. Tested at salt concentrations at which the bacterial strain could grow.
2.3. 16S rRNA Gene Amplification and Phylogeny Analysis
Bacterial strains were cultured on LB agar medium containing 3% NaCl, then incubated at 30°C for 24 hours and observed for colony morphology and mucus production ability. Cells were Gram stained and observed under an optical microscope to determine Gram staining ability, endospore formation ability, and cell shape and size. The bacterial strain was also molecularly identified by 16S rRNA gene sequence analysis. The 16S rRNA gene was amplified through the following PCR cycling profile: initial denaturation at 95°C for 3 minutes, followed by 35 cycles each at 94°C for 45 seconds, at 55°C annealing for 45 seconds, and at 72°C extension for 45 seconds, followed with final elongation at 72°C for 10 minutes. A PCR reaction was performed in a 25 µl volume comprising 2.5 µl of template DNA, 12.5 µl of 2X Taq Master mix, 1 µl of each primer, and 8 µl of deionized water, and the size of the amplified fragments was evaluated by 1% gel electrophoresis. Pairs of primers: 27F (5'-AGAGTTTGATCCTGGCTCAG-3') and 1492R (5'-GGTTACCTTGTTACGACTT-3') [26] were used to amplify the 16S rRNA gene. The amplified samples were sent for sequencing. Bacterial isolates were further confirmed at the species level by BLAST search using the GenBank/EMBL database using the BLAST tool and building a phylogenetic tree using MEGA XI software in the maximum-likelihood method. These sequences have been deposited in GenBank under accession number PP69439.
2.4. Cultivation of Bacterial Strain
The colony was pre-cultured in 5 ml of LB medium, shaking at 200 RPM at 30°C overnight. The purpose of this step is to increase the bacterial population. Then, 5% of the pre-culture medium was transferred to two 100 ml Erlenmeyer flasks containing 30 ml of LB medium without and with 3% NaCl. Shake the flask at 30°C, at 200 RPM for 48 hours. The post-fermentation fluid was measured for OD600 to determine cell growth ability and EPS extraction to evaluate the EPS biosynthesis ability of the bacterial strain.
2.5. Extraction of Exopolysaccharide
The EPS extraction process was conducted based on the method of [1]: A 20 ml aliquot of the culture was diluted 2-fold by volume in distilled water, then heated at 100°C for 10 minutes to inactivate enzymes involved in EPS degradation. After centrifugation at 8,000 RPM for 20 minutes, the supernatant was filtered through a 0.22 µm membrane filter to remove the remaining cells and mixed with two times the volume of cold absolute acetone (4°C), kept at 4°C overnight. Collect the precipitate by centrifugation at 8,000 RPM for 20 minutes and wash twice with acetone to remove impurities. To remove small-sized impurities (simple sugars, salts), crude EPS was dissolved in distilled water and dialyzed (14kDa cut-off dialysis membrane, Himedia, Mumbai, India) in water every 8 hours—water exchange. After 40 hours of dialysis, the sample was kept at −25°C for 16 hours, then lyophilized. Weigh the obtained dry EPS.
2.6. Characterisation of Exopolysaccharide
EPS after extraction is determined for total sugar content using the phenol sulfuric acid method according to Duboi’s method [27] and quantified total protein using the Bradford method [28].
Scanning electron microscopic images of EPS were taken on a JSM-SEM IT200 (JEOL, Japan). The composition ratio of elements, a critical aspect of our research, was determined with high precision by the EDS Dry SD60 detector in the JSM-IT200 electron microscope based on the X-ray energy dispersion spectroscopy (or energy dispersion spectroscopy) method with the effective method ZAF quantitative adjustment. The dynamic laser scattering method determined the particle size distribution and zeta potential distribution of the sample. EPS was dissolved in sterile distilled water at 1 mg/ml concentration to determine the zeta potential [29].
Estimation of EPS molecular weight: 50 mg EPS was dissolved in 100 ml of 0.1M NaNO3 solution for 24 hours [stock solution 0.05% (w/v)]. The stock EPS solution was diluted in 0.1M NaNO3 solution to concentrations of 0.025%; 0.0125%; 0.00625%; 0.003125%; and 0.0015625%. Then, the flow time of the solvent (0.1M NaNO3 solution) and the EPS solutions were measured using a Cannon-Fenske viscometer at 25°C, from which the graph of the dependence of the reduced viscosity on the EPS concentration was constructed and the intrinsic viscosity ([η]) was determined [30,31]:
[η] is the intrinsic viscosity; c is EPS concentration, ηsp is specific viscosity; reduced viscosity ηred = ηsp/c.
From there, estimate the EPS molecular weight based on the Mark-Houwink formula: , in which M is the EPS molecular weight to be calculated, K and α are constants depending on the nature of the solvent and temperature, and α usually has a value in the range of 0.5–0.8 [31].
FT-IR: FT-IR spectra were recorded on an Impac-410 FTIR instrument using KBr crystal compact discs as described previously [32] to determine the functional groups of EPS.
Determination of monosaccharide components of EPS: 20mg of freeze-dried EPS was hydrolyzed with 3 ml of 2M trifluoroacetic acid for 2 hours at 120°C. The sample was then lyophilized and diluted in sterile distilled water, centrifuged at 10,000RPM for 10 minutes, and filtered through a 0.22 μm membrane filter before HPLC analysis. The monosaccharide composition of EPS was analyzed using an Agilent 1,260 HPLC system equipped with a Hi-Plex Ca column (300 × 7.7 mm), an RI detector, and distilled water as the mobile phase. The flow rate was set to 0.6 ml/minute with a run time of 25 minutes. The hydrolyzed EPS sample, along with Sigma-Aldrich standard sugars, was injected into the column. The retention times of the sample were compared to those of the standards.
2.7. Exopolysaccharide’s Water Holding Capacity
Water holding capacity (WHC) is the amount of water retained in 1 g of dry EPS. It is the sum of bound, hydrodynamic, and physically trapped water. Conduct experiments based on the WHC determination by weight change method [33,34]. 50 mg of EPS was added to a 2 ml Eppendorf tube containing 1 ml of distilled water, mixed for 1 minute, kept still every 15 minutes, shaking for 5 seconds, repeated four times, and then centrifuged 5,000RPM at 4°C for 15 minutes. Decant the supernatant to separate the water not held by EPS. Use absorbent paper to absorb all the water remaining on the outside, then weigh the EPS after hydrating. The water-holding capacity of EPS is calculated according to the following formula:
2.8. Water Holding Capacity of Soil Treated with EPS and Strain TSD5
Sample preparation
Used crushed coral sand soil (≤2 mm). The mixed soil consists of crushed coral sand with the addition of 13% substrate and 3% bentonite (*). The substrate has ingredients according to the weight ratio: 3 coconut fibers: 3 smoked husks: 2 sugarcane mud: 2 sugarcane ash.
Design experiments based on publications
Exp.1. 50 g of coral sand soil with 10 ml of distilled water added.
Exp.2. 50 g of mixed soil and 10 ml of distilled water.
Exp.3. 50 g of mixed soil was added to 10 ml of TSD5 strain culture solution (109 cells/ml).
Exp.4. 50 g of mixed soil supplemented with 10 ml of distilled water and 70 mg of crude EPS.
Exp.5. 50 g of mixed soil supplemented with 10 ml of distilled water and 140 mg of crude EPS.
Five corresponding soil samples in the above five experiments were determined the water holding capacity, drainage rate, and aggregation ability. Proceeded based on the "Droplet Counting Method" of Vardharajula and Shaik [35] Brischke and Wegener [36] with modifications:
Step 1: Determine the soil drainage rate
25 ml of water was added to each soil sample of the above 5 experiments, mixed for 1 minute, and left for 2 hours. Whatman filter paper with a diameter of 125 mm was placed at the bottom of the funnel (funnel rim diameter was 70 mm) and moistened with distilled water so that the filter paper adhered closely to the funnel. The funnel is placed on the measuring cylinder. The prepared test sample was transferred to the funnel and spread evenly, adding 25 ml of distilled water to the funnel. Calculate the time it takes for 20 ml of water to flow out of the funnel, then calculate the drainage rate (ml/second).
Step 2: Determine the soil aggregation capacity and water holding capacity of the soil
The soil in the step 1 experimental funnels was drained of water. 5 mg of each sample was taken to take an SEM image to observe the surface and evaluate the ability of EPS to agglomerate in the experimental soil samples. The remaining soil is placed on a glass dish of known mass and weighed. The dish containing the soil sample was dried at a temperature of 103°C ± 2°C and weighed again. The WHC of the soil samples was calculated as follows:
WHC is the water holding capacity of the soil, expressed in %; msoil,saturated is the mass of saturated soil, in g; msoil,0 is the mass of dried soil, in g.
2.9. Evaluation of The Salinity Reduction Potential of Free Water In Soil
Five experiments were designed with mixed soil samples (*):
Exp.1: 50 g of mixed soil and 10 ml of distilled water
Exp.2: 50 g of mixed soil and 10 ml of 3% NaCl solution
Exp.3: 50 g of mixed soil, 70 mg of EPS, and 10 ml of 3% NaCl solution
Exp.4: 50 g of mixed soil, 0.3 g of NaCl, and 10 ml of LB medium
Exp.5: 50 g of mixed soil, 0.3 g of NaCl, and 10 ml of TSD5 strain culture solution in LB medium (109 cells/ml).
Each experiment was repeated 3 times.
In each experiment, mix well and let stand for 24 hours, then mix with water in a ratio of 1:5 (soil: water, w/w), shake for 1 hour, and put into a funnel lined with Whatman filter paper to collect the water flowing out. Measured EC of the collected water samples using a Total Meter EZ-9909SP electrical conductometer.
2.10. Statistical Analysis
All experiments were repeated three times. Statistical differences were determined by One-way ANOVA using Minitab Statistical Software. Differences were considered statistically significant when p < 0.05 according to the Terkey method.
3. RESULTS AND DISCUSSION
3.1. Salt Tolerance of Bacterial Strain TSD5
Strain TSD5 can grow on LB agar medium supplemented with 0%–12.5% NaCl (Fig. 1). At a concentration of 15%, the strain grew very poorly, and colonies were much smaller at lower NaCl concentrations. Strain TSD5 cannot grow at 20% NaCl concentration. This is a high result compared to some publications on salt-tolerant strains such as three strains of three species: Bacillus paramycoides, Bacillus amyloliquefaciens, and Bacillus pumilus, which can tolerate salt from 2% to 10% [24]. EPS-producing Rahnella aquatilis JZ-GX1 is tolerant of 0%–9% NaCl and grows well at 3% concentration [25]. Virgibacillus dokdonensis VITP14 bacteria has salt tolerance at NaCl salt concentrations of 0%–10% [29]. However, the salt tolerance of strain TSD5 is still lower than strain Bacillus subtilis LR-1, which can grow in 160 g/l NaCl (16%) environment [37].
![]() | Figure 1. Growth ability strain TSD5 on LB agar medium without and with different concentrations of NaCl after 46 hours incubation at 30°C. [Click here to view] |
3.2. Identification of Bacterial Strain
The bacterial strain TSD5 has been morphologically described and molecularly identified (sequencing of the 16S rRNA gene segment). The colony is opaque white in shape, has a shiny surface, and has mucus on the edges (Fig. 2a). Under the microscope, the strain’s cells are rod-shaped, gram-positive, 2–3 µm, and capable of producing endospores (Fig. 2b). The sequenced 16S rRNA gene segment of bacterial strain TSD5 is 1422 bp in length. The partial 16S rRNA of TSD5 strain has been deposited in the GenBank with accession number PP694391. The genes were analyzed and aligned with corresponding genes on GenBank to create a phylogenetic tree, as depicted in Figure 2c. The isolated strain TSD5 has the 16S rRNA gene sequence most similar to B. velezensis strain NR116240 (99.8%). The genus Bacillus has been published to have salt-tolerant strains such as Bacillus megaterium NCT-2 [38], B. paramycoides, B. amyloliquefaciens, and B. pumilus [24]. B. subtilis, B. megaterium, B. cereus, B. amyloliquefaciens, B. pumilus, Bacillus licheniformis, B. endophyticus, B. atrophaeus, B. safensis, B. mojavensis [39]; and produce EPS such as B. velezensis KY498625 [40], B. proteolyticus A27 [41], B. licheniformis DM-1 [42] or has both salt tolerance and EPS production such as B. subtilis LR-1 [37], Bacillus tequilensis, and Bacillus aryabhattai [43]. Bacillus species are assessed to have good metabolism/genome and spore formation and are highly resilient to abiotic stresses, helping to enhance plant resistance to saline soils [39]. The functional groups of EPS can help bind and complex with Na+ in soil and thus reduce plant exposure to this ion under saline conditions [39]. According to TRBA 466 of the European Union, B. velezensis belongs to Biosafety Level 1 and can be used without restriction in agriculture and the environment.
![]() | Figure 2. The digital image of colony (a), electron microscopic image of cell (b), and Phylogenetic tree was built from the 16 rRNA gene sequence-ralated strains on GenBank (c) of strain TSD5. [Click here to view] |
Bacillus velezensis strains are known for their ability to improve soil contaminated with heavy metals [44], enrich the soil microbiota, improve the efficiency of soil nutrients, solubilize inorganic phosphorus, fix nitrogen, produce indole-3-acetic acid, and tolerate salt well [20]. These are rhizosphere microorganisms with the ability to form biofilms that enhance symbiotic cooperation with soil microorganisms, promote growth, inhibit disease, and reduce stress on plants [45,46].
3.3. Characterisation of Exopolysaccharide
Table 1 shows that strain TSD5 grows and produces EPS well at NaCl concentrations of 0%–3%. The strain grows better in the environment without NaCl (OD600 = 10.53). However, under NaCl stress conditions, this bacterial strain promotes EPS production better (1.25 g/l), especially since the total sugar and total protein content in EPS are also 2 times higher than in the condition without NaCl supplementation. The differences here are all statistically significant, p < 0.05. Increased EPS production under salt stress conditions resulted in increased cell viability, as EPS plays an important role in biofilm formation. Biofilm formation increases the resistance of EPS-producing cells [47], and also increases soil aggregation, water, and nutrient uptake, which helps microorganisms in the biofilm, as well as plants, to withstand adverse environmental conditions [9].
![]() | Table 1. Effect of NaCl stress conditions on growth and EPS production of bacterial strain TSD5. [Click here to view] |
The SEM results on Figure 3a,b show that the EPS sample has a structure consisting of discrete particles, 1–20 µm in size from the medium without NaCl added (Fig. 3a), while the EPS from the medium supplemented with 3% NaCl consists of particles covered by a layer of glue that helps bind the components in the sample (Fig. 3b). This is because EPS from the NaCl-stressed environment has a much higher polysaccharide and protein content (more than 2 times) than the environment without NaCl salt, thereby increasing the viscosity and colloidal properties of EPS [9]. The elemental composition of EPS was detected by the EDX spectrum in Figure 3c,d. The EPS sample from a NaCl-free environment includes 11 elements C, N, O, Na, Mg, P, S, Cl, K, Ca, and Zn, with 2 main elements C and O accounting for 32.44% and 42.9% by mass, respectively (Fig. 3c). However, EPS separated from NaCl-containing medium did not appear Zn and Ca, and only had 9 elements, including C (32.80%) and O (40.40%) (Fig. 3d). The results show the effect of NaCl on the ion adsorption capacity of EPS. In addition, Na and Cl content only account for 0.73% and 0.56%, respectively, in EPS from the NaCl-free environment, while accounting for a larger amount in EPS from the salt-added environment, 8.40% and 2.04%, respectively. It has been shown that when the environment is salty, EPS increases the adsorption of both Na and Cl, helping to reduce the free NaCl concentration in the solution (reducing salinity). EPS or EPS-producing bacterial strains that help reduce soil salinity have been reported by some [9,10].
![]() | Figure 3. SEM images and EDX spectrum of EPS samples cultured in an environment without added NaCl salt (a, c) and in an environment supplemented with 3% NaCl environment (b, d). [Click here to view] |
The presence of cations such as Ca, Mg, Na, Ca, Zn, and K shows the ability of EPS to adsorb cations. This is explained by the fact that EPS is a polyanion with a highly charged zeta potential of −30.1mV (Fig. 4a), as it contains negatively charged functional groups and thus has the ability to adsorb cations [48,49]. S and P are also present in EPS, which are anionic functional groups thought to be attached to the sugar ring to help transfer these negative charges in EPS [29], helping to bind cations [50]. Furthermore, S present in EPS is also a characteristic feature of marine bacteria [10,29]. The EPS sample of B. velezensis TSD5 had a zeta potential of −30.1mV, indicating anionic properties can adsorb cations. EPS reported a wide range of negative zeta potentials: −3.44mV in Enterococcus sp. F2 [34]; Paenibacillus tarimensis REG 0201M −35.2mV [49]; −33.83mV in B. velezensis P1 [51].
![]() | Figure 4. Zeta potential distribution of EPSTSD5 (a); Dependence of reduced viscosity on EPS concentration in 0.1M NaNO3 solution at 25°C (b); FTIR spectrum with main functional groups of EPS TSD5 (c). [Click here to view] |
EPS molecular weight is estimated based on intrinsic viscosity. Based on the graph in Figure 4b, the intrinsic viscosity [η] was determined to be 0.6514 dl/g, combined with the Mark–Houwink formula: , in which α = 0.687, K = 2.259 × 10−4 [31], from here the molecular weight of EPS was determined to be 1.09 × 105Da. Compared with previous publications on the molecular weight of EPS from B. velezensis strains, this result is equivalent to EPSKY471306 [40]; lower than the mass of EPS-SN-1 reaching 2.21 × 105Da [52], but higher than EPSF6 reaching 2.7 × 104Da [53] and MHM3 (1.145 × 104Da) [54]. The intrinsic viscosity of EPS in strain TSD5 was 0.6514dl/g, higher than that in Virgibacillus salarius BM02 at 0.12–0.54dl/g [55] but lower than that in B. megaterium at 5.2dl/g [56]. However, intrinsic viscosity is also greatly influenced by the environment and culture conditions [55]. The higher the intrinsic viscosity, the longer and more complex the polymer chains are, resulting in higher strength and stiffness.
FT-IR spectrum (Fig. 4c) provided further evidence for the presence of carbohydrates and proteins in EPS. The broad spectral bands characteristic of the presence of polysaccharides were the bands from 4,000 to 2,500 cm-1 [57], 1,200–900 cm-1 [58]. Specifically, the maximum peak band at 3,429 cm-1 is characteristic of the abundant hydroxyl (-OH) group in polysaccharides [57,52], and the weak bands at 2,925 cm-1 and 2,853 cm-1 are attributed to the stretching of the C-H group in the methylene group [59], the peak at 1,068 cm-1 represents the presence of the C-O group [58]. The spectral band 1,700–1,200 cm-1 is characteristic of protein [58], in which the peaks 1,640 cm-1, 1,586 cm-1 are the signs of C-O [52] and C = O [3] groups, respectively, the peaks 1,413 cm-1 and 1,384 cm-1 indicate the presence of carboxyl group (COO-) [40], besides the band 1,500–1,320 cm-1 is also assigned to methylene group (-CH2) [32]. The infrared spectrum of EPS in some strains of B. velezensis also gave similar results with the appearance of a large band of O-H with an absorption peak at about 3,000 cm-1 such as 3,387.19 cm-1 [52], 3,428.76 cm-1 [40]; in addition, the C-H stretching groups peaked at about 2,928.24 cm-1 [52]; the corresponding C-O group peaked at 1,640 cm-1 [52]; the carboxyl group peaked near 1,447–1,380 cm-1 [40]; in addition, the region 1,200–950 cm-1 (also known as the fingerprint region) is characteristic for each polysaccharide [40].
HPLC results (Fig. 5) recorded the presence of monosaccharides glucose: rhamnose: mannose with a ratio of 1.00: 1.83: 14.20 in the EPSTSD5 hydrolyzed sample, in which mannose accounted for the majority. This result is quite different from some other publications on EPS from B. velezensis strains containing monosaccharides such as fructose and glucose [1]; glucose, mannose, and galactose [40]; mannose (63.52% ) and glucose [3]; glucuronic acid, glucose, fructose, and rhamnose (4.00: 2.00: 1.00: 0.13) [54]. This is explained by the fact that the EPS biosynthesis process in bacteria is quite complex, occurring through many pathways, each of which shares a number of key conserved enzymes. In addition, environmental conditions also affect the structure and branching of EPS [60].
![]() | Figure 5. HPLC results of standard monosaccharides (a) and hydrolyzed EPSTSD5 sample (b). [Click here to view] |
Thus, through analysis of the properties of EPS, it is shown that this is a heteropolymer consisting of monosaccharides mannose, rhamnose, and glucose, with a molecular weight of about 1.09 × 105Da, has a negative zeta potential (capable of cation adsorption), contains hydrophilic functional groups, and has the ability to adsorb metals such as carboxyl, and hydroxyl. To increase the ability to withstand salinity stress, strain TSD5 increases EPS production as well as increases the protein and sugar content in EPS to create more colloidal EPS and adsorb more Na, and Cl than in non-saline conditions. These are the properties that help EPS retain water and reduce salinity.
3.4. Exopolysaccharide’s WHC
The WHC test results in Figure 6a show that the EPS size increases with time after soaking in water for 1–2 hours. The data in Figure 6b show similar results, with WHC reaching 993.33% after 1 hour of soaking in water. The result is higher than some WHC reports of EPS from Lactobacillus kefiranofaciens ZW3 reaching 496.00% [61], EPS-F2 from Enterococcus sp. F2 is 882.5%. EPS after 2 hours of soaking in water for WHC reached 1,740% (Fig. 6b), and the weight increased to 0.87 g (initial dry EPS amount was 50 mg), 1.75 times higher than after 1 hour of soaking in water. The test increased to 4 hours of soaking in water showed that WHC increased insignificantly compared to after 2 hours (p > 0.05), proving that after 2 hours, the hydrated EPS has reached its maximum value (saturated water), so soaking in water for longer but the WHC did not increase significantly. WHC is an essential indicator of EPS; the higher the WHC, the better the water retention ability, and the less water is separated. Therefore, EPS from the TSD5 bacterial strain has a high water retention capacity, promising to bring good water retention capacity to the soil. WHC is one of the functional properties of EPS that is greatly influenced by factors such as molecular weight, particle size, ionic form, and composition of the polysaccharides [33,1]. This property is due to EPS containing high levels of polysaccharides, especially under salt-stress conditions. Polysaccharides are hydrophilic in nature, contributing to the formation of gel networks [62], while proteins are hydrophobic [63] and can interact with polysaccharides through covalent interactions. Non-covalent protein/polysaccharide interactions are important for colloidal stability and soil aggregation ability [62]. Polysaccharides contain various hydrophilic functional groups, such as carboxyl, hydroxyl (shown in the FT-IR analysis results), and phosphate groups [64].
![]() | Figure 6. Image (a) and graph (b) of water holding capacity of EPSTSD5 initially and after 1–4 hours of hydration. Values are presented as mean ± SD; n = 3. [Click here to view] |
The above test proved that EPSTSD5 has a good water retention capacity (1740%) as predicted when analyzing EPS characteristics, promising to help increase the water retention capacity of the soil.
3.5. Water Holding Capacity of Soil Treated with EPS and Strain TSD5
Figure 7A shows that the coral sand soil sample (Exp.1) has the highest water drainage rate (0.94 ml/second), 18.8 times higher than the worst-drained mixed soil sample in Exp.2. The coral sand sample (Exp.1) drained quickly due to its loose structure, so water easily drains through the gaps between sand grains. However, in the mixed soil sample (Exp.2), bentonite particles were added that have the ability to expand to help seal the gaps between the sand grains, helping to retain water for the longest time. In Exp. 3,4,5, the drainage rate is 2.4–3.6 times higher than sample Exp.2 due to the addition of EPS/EPS fermentation solution that helps bind soil components together to form aggregates [35]. There are gaps between the agglomerated particles to help water circulate and drain better in soil samples without EPS addition [65]. The EPS content in Exp.5 is twice as high as in Exp. 4, so it can create more agglomerates, thus better drainage capacity. However, in practice, the drainage rate in Exp. 5 was higher than that in Exp. 4 (Fig. 7A), but this difference was not statistically significant (p > 0.05). Figure 7B shows that the WHC in Exp. 4 and 5 with added EPS/EPS-producing strain culture broth was significantly higher than that in the samples without added EPS in Exp. 1 and 2 (p < 0.05). The WHC in Exp.5 (EPS content 140 mg) is higher than in Exp.4 (70 mg EPS) and 1.35 times higher in Exp.2 (mixed soil, no EPS), 1.96 times higher than with Exp.1 (coral sand sample). The WHC in Exp.2 is higher than Exp.1 due to the addition of bentonite to retain water. Exp.3–5, in addition to bentonite, also adds EPS/culture solution of the TSD5 strain that produces EPS; EPS has the ability to retain water, so WHC is higher than in Exp.2, p < 0.05.
![]() | Figure 7. Drainage rate (A); WHC (B); images of the experimental samples after 2 hours of soaking the soil samples in water (C) and after filtering the water on a funnel (D); and SEM images of the surface of 5 soil samples after testing (E) by the droplet counting method. Exp.1, coral sand soil. Exp.2, mixed soil (coral sand with the addition of 13% substrate and 3% bentonite; the substrate has the following mass ratios: 3 coconut fibers: 3 smoked husks: 2 sugarcane mud: 2 sugarcane ash). Exp.3, mixed soil with TSD5 strain culture solution. Exp.4, mixed soil with 70 mg of EPS. Exp.5, mixed soil with 140 mg of EPS. Values are presented as mean ± SD; n = 3. [Click here to view] |
Visual observation in Figure 7C and D shows that, after soaking in water for 2 hours, sample Exp.2 has a clear layer separation phenomenon by weight, with a white layer (coral sand) underneath and a layer of light organic medium in the upper layer (black). In Exp.3–5, the layer separation phenomenon is significantly improved, and the black substrate has been mixed evenly with sand. Because in Exp.3–5, EPS/culture fluid containing EPS is added, it helps bind the soil components together to form aggregates [35], making it more difficult to layer. The SEM results (Fig. 7E) contribute to confirming the above argument. On the soil samples supplemented with EPS or the culture solution of EPS-producing strain TSD5 (Exp.3–5), there was a phenomenon of agglomeration of particles together, forming larger blocks, with no or very few single small particles left as on Exp.1 and 2 without EPS. Agglomeration creates gaps between particles, allowing water to circulate better. Therefore, Exp. 4 and 5 (Fig. 7A) had a faster drainage rate than on Experiment 2 (without EPS). The above agglomeration phenomenon is due to EPS clinging to the soil surface through hydrogen bonding, cation bonding, anion adsorption, and van der Waal forces. Soil agglomeration improves soil structure and provides soil stability [9].
The above experiments have proven that EPSTSD5 and the TSD5 strain fermentation solution have the ability to bind soil components, and increase aggregation and water retention capacity for soil as previously predicted.
3.6. The ability to reduce soil salinity of EPS and TSD5 strain
The data in Figure 8 show that when treating soil with EPS or culture fluid of the EPS-producing TSD5 strain, the EC in the collected water samples (free water) was reduced by about half. This is explained by the fact that EPS has the ability to adsorb NaCl (shown in the EDX analysis results of EPS). The results contribute to confirming the salinity reduction ability of EPS as well as EPS-producing bacteria. This is very useful to improve saline soil and increase plant survival by absorbing salt from the soil, helping to reduce the salinity of free water in the soil, protecting the roots, increasing the ability of the roots to absorb water and nutrients, and promoting plant growth and development [9]. The ability to reduce salinity here is due to EPS having a very negative zeta potential and containing many negatively charged functional groups (as presented in Section 3.3), so it has the ability to adsorb cations, including Na+. The mechanisms of cation adsorption of EPS include: complexation, biological precipitation, ion exchange, and oxidation-reduction [13]. EPS acts as a barrier to protect bacterial cells and plant roots from high salinity due to its ability to aggregate, bind soil components and even roots, and form complexes with metals, including sodium, thereby reducing the effects of high soil salinity and reducing salt stress by maintaining the Na+/K+ balance that helps plants survive under adverse soil conditions [13]. EPS functional groups such as hydroxyl, carboxyl, carbonyl, amine, imidazolic, and phosphonate groups possess different metal binding affinities and can reduce the concentration of free metal ions. Therefore, increasing EPS production under metal stress helps reduce their toxicity to bacterial cells as well as plants through complexation or reduction reactions [66].
![]() | Figure 8. The EC values of water samples from five soil salinity reduction experiments. Exp.1. non-saline control; Exp.2. salt addition; Exp.3. EPS and salt addition; Exp.4. salt and LB medium addition; Exp.5. salt and culture solution of strain TSD5 addition. Values are presented as mean ± SD; n = 3, p < 0.05. [Click here to view] |
Salinity and soil structure are extremely important factors that determine soil health and plant growth. The results of the study contribute to explaining the water retention and salinity reduction mechanisms of EPS as well as EPS-producing bacteria. This is an important key to opening up directions for application in improving dry, saline soil, and enhancing soil health and sustainability. This demand is huge because the area of dry, saline soil is expanding worldwide due to the impact of climate change as well as unreasonable human farming activities (irrational use of chemical fertilizers, pesticides, saltwater irrigation, and so on). It is estimated that by 2050, up to 50% of the cultivated land area will be affected by salinity [9]. Currently, B. velezensis is considered a safe microorganism, being developed in microbial fertilizer preparations for soil improvement. This is a reasonable solution to replace chemical fertilizers and develop sustainable agriculture [44]. Moreover, with the properties of EPS discovered in this study, such as EPS having a large molecular size, very negative zeta potential, having many negatively charged functional groups, and having good adhesion ability, it helps to open up further research directions on the ability to adsorb heavy metals, adsorb nutrients, and the ability to promote the development of beneficial microorganisms in the root zone for plants. In addition, many other useful properties of B. velezensis have been discovered in previous studies, such as the ability to dissolve inorganic phosphorus and plant growth stimulants, helping plants increase their resistance to non-metallic stress (heavy metals, pH, temperature, drought, and so on) as well as plant pathogenic microorganisms [44,20,45,46]. This study has opened up great prospects for applying the EPS-producing B. velezensis TSD5 strain to improve the soil as well as overcome environmental pollution problems. However, the limitation is that EPS here only has the effect of absorbing salt; the salt is still in the soil, only temporarily preventing the salt from moving with water, thereby temporarily avoiding the impact of salinity on plant roots. Therefore, in the long term, it is still necessary to have effective measures to coordinate the use of beneficial microorganisms with other field management measures to increase the effectiveness of treating saline soil. Up to now, the ecological risks of introducing EPS-producing microorganisms into the natural environment have not been discovered. However, having more assessments on the long-term safety of EPS-producing bacteria to the environment and humans is very meaningful. In addition, long-term field trials and studies on the effects of B. velezensis TSD5 and EPS-enriched soil on plant growth, especially coral soil-related crops, are urgently needed for sustainable agricultural development.
4. CONCLUSION
The study isolated the salt-tolerant, EPS-producing B. velezensis TSD5 strain from coral sand on a coral island in Khanh Hoa province, Vietnam. The strain TSD5, which exhibits salt tolerance ranging from 0% to 12.5% NaCl, produced EPS under 3% NaCl salinity stress condition at 1.25 g/l, which was better than in non-saline conditions. Strain TSD5 shares a 16S rRNA gene sequence identical to B. velezensis NR116240 (99,8%), a Biosafety Level 1 species. The EPS produced by strain TSD5 is characterized by a large molecular weight and consists of monosaccharides mannose, glucose, and rhamnose, containing many hydrophilic and negatively charged functional groups. It is a polyanion with significant NaCl adsorption and water-hoding capacity. The application of EPS or culture liquid of the TSD5 strain to soil improved soil aggregate formation and water retention and also helped reduce soil salinity. Overall, these findings highlight the potential of EPS derived from B. velezensis TSD5 in the remediation of arid, saline soils, suggesting its promising applications in agriculture and environmental remediation.
5. ACKNOWLEDGMENT
This research was financially supported by the Joint Vietnam - Russia Tropical Science and Technology Research Center.
6. CONFLICTS OF INTEREST
The authors report no financial or any other conflicts of interest in this work.
7. ETHICAL APPROVALS
The article does not contain any studies involving humans or animals performed by the author.
8. AUTHOR CONTRIBUTIONS
All authors made substantial contributions to conception and design, acquisition of data, or analysis and interpretation of data; took part in drafting the article or revising it critically for important intellectual content; agreed to submit to the current journal; gave final approval of the version to be published; and agreed to be accountable for all aspects of the work. All the authors are eligible to be authors as per the International Committee of Medical Journal Editors (ICMJE) requirements/guidelines.
9. DATA AVAILABILITY
The authors confirm that the data supporting the findings of this study are available within the article.
10. PUBLISHER’S NOTE
All claims expressed in this article are solely those of the authors and do not necessarily represent those of the publisher, the editors and the reviewers. This journal remains neutral with regard to jurisdictional claims in published institutional affiliation.
11. USE OF ARTIFICIAL INTELLIGENCE (AI)-ASSISTED TECHNOLOGY
The authors declare that they have not used artificial intelligence (AI) tools for writing and editing of the manuscript, and no images were manipulated using AI.
REFERENCES
1. Vu THN, Quach NT, Nguyen NA, Nguyen HT, Ngo CC, Nguyen TD, et al. Genome mining associated with analysis of structure, antioxidant activity reveals the potential production of levan-rich exopolysaccharides by food-derived Bacillus velezensis VTX20. Appl Sci 2021;11(15):7055. CrossRef
2. Wang M, Hu T, Lin X, Liang H, Li W, Zhao S, et al. Probiotic characteristics of Lactobacillus gasseri TF08-1: a cholesterol-lowering bacterium, isolated from human gut. Enzyme Microb Technol 2023;169:110276. CrossRef
3. Chirakkara SP, Abraham A. Exopolysaccharide from the mice ovarian bacterium Bacillus velezensis OM03 triggers caspase-3-dependent apoptosis in ovarian cancer cells. J Appl Pharm Sci 2023;13(6):154–64. CrossRef
4. Raposo MF, de Morais AM, de Morais RM. Influence of sulphate on the composition and antibacterial and antiviral properties of the exopolysaccharide from Porphyridium cruentum. Life Sci 2014;101(1-2):56–63. CrossRef
5. Song M, Wang J, Bao K, Sun C, Cheng X, Li T, et al. Isolation, structural characterization and immunomodulatory activity on RAW264.7 cells of a novel exopolysaccharide of Dictyophora rubrovalvata. Int J Biol Macromol 2024;270(Pt 2):132222. CrossRef
6. Paul S, Parvez SS, Goswami A, Banik A. Exopolysaccharides from agriculturally important microorganisms: conferring soil nutrient status and plant health. Int J Biol Macromol 2024;262(Pt 2):129954. CrossRef
7. Li Y, Narayanan M, Shi X, Chen X, Li Z, Ma Y. Biofilms formation in plant growth-promoting bacteria for alleviating agro-environmental stress. Sci Total Environ 2024;907:167774. CrossRef
8. Netrusov AI, Liyaskina EV, Kurgaeva IV, Liyaskina AU, Yang G, Revin VV. Exopolysaccharides producing bacteria: a review. Microorganisms 2023;11(6):1541. CrossRef
9. Bhagat N, Raghav M, Dubey S, Bedi N. Bacterial exopolysaccharides: insight into their role in plant abiotic stress tolerance. J Microbiol Biotechnol 2021;31(8):1045–59. CrossRef
10. Singh RP, Shukla MK, Mishra A, Kumari P, Reddy CRK, Jha B. Isolation and characterization of exopolysaccharides from seaweed associated bacteria Bacillus licheniformis. Carbohydrate Polymers 2011;84(3):1019–26. CrossRef
11. Awasthi S, Srivastava P, Mishra PK. Application of EPS in agriculture: an important natural resource for crop improvement. Outlook Agric 2017;27:219–24. CrossRef
12. Mukherjee P, Mitra A, Roy M. Halomonas rhizobacteria of Avicennia marina of Indian Sundarbans promote rice growth under saline and heavy metal stresses through exopolysaccharide production. Front Microbiol 2019;10:1207. CrossRef
13. Zhang H, Wang K, Liu X, Yao L, Chen Z, Han H. Exopolysaccharide producing bacteria regulate soil aggregates and bacterial communities to inhibit the uptake of cadmium and lead by lettuce. Microorganisms 2024;12(11):2112. CrossRef
14. Chen Q, Qiu Y, Yuan Y, Wang K, Wang H. Biocontrol activity and action mechanism of Bacillus velezensis strain SDTB038 against Fusarium crown and root rot of tomato. Front Microbiol 2022;13:994716. CrossRef
15. Medhioub I, Cheffi M, Tounsi S, Triki MA. Study of Bacillus velezensis OEE1 potentialities in the biocontrol against Erwinia amylovora, causal agent of fire blight disease of rosaceous plants. Biol Control 2022;167:104842. CrossRef
16. Keshmirshekan A, de Souza Mesquita LM, Ventura SP. Biocontrol manufacturing and agricultural applications of Bacillus velezensis. Trends Biotechnol 2024;42(8):986–1001. CrossRef
17. Zhang J, Zhao L, Tang W, Li J, Tang T, Sun X, et al. Characterization of a novel circular bacteriocin from Bacillus velezensis 1-3, and its mode of action against Listeria monocytogenes. Heliyon 2024;10(9):e29701. CrossRef
18. Zanon MSA, Cavaglieri LR, Palazzini JM, Chulze SN, Chiotta ML. Bacillus velezensis RC218 and emerging biocontrol agents against Fusarium graminearum and Fusarium poae in barley: in vitro, greenhouse and field conditions. Int J Food Microbiol 2024;413:110580. CrossRef
19. Pham MP, Le XD, Nguyen DL, Vu DD. Characteristics habitat and molecular identity of Calophyllum inophyllum L.(Calophyllaceae) in Spratly Islands, Vietnam. Res J Biotech 2022;17(6):149–57. CrossRef
20. Shi H, Lu L, Ye J, Shi L. Effects of two Bacillus velezensis microbial inoculants on the growth and rhizosphere soil environment of Prunus davidiana. Int J Mol Sci 2022;23(21):13639. CrossRef
21. Mahdi I, Allaoui A, Fahsi N, Biskri L. Bacillus velezensis QA2 potentially induced salt stress tolerance and enhanced phosphate uptake in quinoa plants. Microorganisms 2022;10(9):1836. CrossRef
22. Derdak R, Sakoui S, Pop OL, Vodnar DC, Addoum B, Elmakssoudi A, et al. Screening, optimization and characterization of exopolysaccharides produced by novel strains isolated from Moroccan raw donkey milk. Food Chem: X 2022;14:100305. CrossRef
23. Ramya P, Sangeetha D, Anooj E, Gangadhar L. Isolation, identification and screening of exopolysaccharides from marine bacteria. Ann Trop Med Public Health 2020;23(2020):23–940. CrossRef
24. Sharma A, Dev K, Sourirajan A, Choudhary M. Isolation and characterization of salt-tolerant bacteria with plant growth-promoting activities from saline agricultural fields of Haryana, India. J Genet Eng Biotechnol 2021;19(1):99. CrossRef
25. Li PS, Kong WL, Wu XQ. Salt tolerance mechanism of the rhizosphere bacterium JZ-GX1 and its effects on tomato seed germination and seedling growth. Front Microbiol 2021;12:657238. CrossRef
26. Miller CS, Handley KM, Wrighton KC, Frischkorn KR, Thomas BC, Banfield JF. Short-read assembly of full-length 16S amplicons reveals bacterial diversity in subsurface sediments. PLoS One 2013;8(2):e56018. CrossRef
27. DuBois M, Gilles KA, Hamilton JK, Rebers Pt, Smith F. Colorimetric method for determination of sugars and related substances. Anal Chem 1956;28(3):350–6. CrossRef
28. Bradford MM. A rapid and sensitive method for the quantitation of microgram quantities of protein utilizing the principle of protein-dye binding. Anal Biochem 1976;72(1-2):248–54. CrossRef
29. Andrew M, Jayaraman G. Molecular characterization and biocompatibility of Exopolysaccharide produced by moderately halophilic bacterium Virgibacillus dokdonensis from the Saltern of Kumta Coast. Polymers 2022;14(19):3986. CrossRef
30. Yacob N. Determination of viscosity-average molecular weight of chitosan using intrinsic viscosity measurement. J Nucl Related Technol 2013;10(01):40–4.
31. Shao L, Wu Z, Tian F, Zhang H, Liu Z, Chen W, et al. Molecular characteristics of an exopolysaccharide from Lactobacillus rhamnosus KF5 in solution. Int J Biol Macromol 2015;72:1429–34. CrossRef
32. Cheah C, Cheow YL, Ting ASY. Co-cultivation, metal stress and molasses: strategies to improving exopolymeric yield and metal removal efficacy. Sustain Environ Res 2022;32(1):9. CrossRef
33. Insulkar P, Kerkar S, Lele SS. Purification and structural-functional characterization of an exopolysaccharide from Bacillus licheniformis PASS26 with in-vitro antitumor and wound healing activities. Int J Biol Macromol 2018;120:1441–50. CrossRef
34. Jiang G, Gan L, Li X, He J, Zhang S, Chen J, et al. Characterization of structural and physicochemical properties of an exopolysaccharide produced by Enterococcus sp. F2 from fermented soya beans. Front Microbiol 2021;12:744007. CrossRef
35. Vardharajula S, Shaik ZA. Exopolysaccharide production by drought tolerant Bacillus spp. and effect on soil aggregation under drought stress. J Microbiol Biotechnol Food Sci 2014;4(1):51–7. CrossRef
36. Brischke C, Wegener FL. Impact of water holding capacity and moisture content of soil substrates on the moisture content of wood in terrestrial microcosms. Forests 2019;10(6):485. CrossRef
37. Zhao X, Chen G, Wang F, Zhao H, Wei Y, Liu L, et al. Extraction, characterization, antioxidant activity and rheological behavior of a polysaccharide produced by the extremely salt tolerant Bacillus subtilis LR-1. LWT 2022;162:113413. CrossRef
38. Wang B, Zhang D, Chu S, Zhi Y, Liu X, Zhou P. Genomic analysis of Bacillus megaterium NCT-2 reveals its genetic basis for the bioremediation of secondary salinization soil. Int J Genom 2020;2020(1):4109186. CrossRef
39. Ibarra-Villarreal AL, Gándara-Ledezma A, Godoy-Flores AD, Herrera-Sepúlveda A, Díaz-Rodríguez AM, Parra-Cota FI. Salt-tolerant Bacillus species as a promising strategy to mitigate the salinity stress in wheat (Triticum turgidum subsp. durum). J Arid Environ 2021;186:104399. CrossRef
40. Moghannem SAM, Farag MMS, Shehab AM, Azab MS. Exopolysaccharide production from Bacillus velezensis KY471306 using statistical experimental design. Braz J Microbiol 2018;49(3):452–62. CrossRef
41. Cheng C, Shang-Guan W, He L, Sheng X. Effect of exopolysaccharide-producing bacteria on water-stable macro-aggregate formation in soil. Geomicrobiol J 2020;37(8):738–45. CrossRef
42. Fan Y, Wang J, Gao C, Zhang Y, Du W. A novel exopolysaccharide-producing and long-chain n-alkane degrading bacterium Bacillus licheniformis strain DM-1 with potential application for in-situ enhanced oil recovery. Sci Rep 2020;10(1):8519. CrossRef
43. Shultana R, Kee Zuan AT, Yusop MR, Saud HM. Characterization of salt-tolerant plant growth-promoting rhizobacteria and the effect on growth and yield of saline-affected rice. PLoS One 2020;15(9):e0238537. CrossRef
44. Zhong X, Jin Y, Ren H, Hong T, Zheng J, Fan W, et al. Research progress of Bacillus velezensis in plant disease resistance and growth promotion. Front Ind Microbiol 2024;2:1442980. CrossRef
45. Sun X, Xu Z, Xie J, Hesselberg-Thomsen V, Tan T, Zheng D, et al. Bacillus velezensis stimulates resident rhizosphere Pseudomonas stutzeri for plant health through metabolic interactions. ISME J 2022;16(3):774–87. CrossRef
46. Xie J, Sun X, Xia Y, Tao L, Tan T, Zhang N, et al. Bridging the gap: biofilm-mediated establishment of Bacillus velezensis on Trichoderma guizhouense mycelia. Biofilm 2024;8:100239. CrossRef
47. Qurashi AW, Sabri AN. Bacterial exopolysaccharide and biofilm formation stimulate chickpea growth and soil aggregation under salt stress. Braz J Microbiol 2012;43:1183–91. CrossRef
48. Nkoh JN, Yan J, Hong ZN, Xu RK, Kamran MA, Jun J, et al. An electrokinetic perspective into the mechanism of divalent and trivalent cation sorption by extracellular polymeric substances of Pseudomonas fluorescens. Colloids Surf B Biointerfaces 2019;183:110450. CrossRef
49. Boukhelata N, Taguett F, Kaci Y. Characterization of an extracellular polysaccharide produced by a Saharan bacterium Paenibacillus tarimensis REG 0201M. Ann Microbiol 2019;69:93–106. CrossRef
50. Maciejewska A, Lugowski C, Lukasiewicz J. First report on the Streptococcus gallolyticus (S. bovis biotype I) DSM 13808 exopolysaccharide structure. Int J Mol Sci 2022;23(19):11797. CrossRef
51. Binmad S, Numnuam A, Kaewtatip K, Kantachote D, Tantirungkij M. Characterization of novel extracellular polymeric substances produced by Bacillus velezensis P1 for potential biotechnological applications. Polym Adv Technol 2022;33(8):2470–9. CrossRef
52. Cao C, Liu Y, Li Y, Zhang Y, Zhao Y, Wu R, et al. Structural characterization and antioxidant potential of a novel exopolysaccharide produced by Bacillus velezensis SN-1 from spontaneously fermented Da-Jiang. Glycoconj J 2020;37:307–17. CrossRef
53. Alharbi MA, Alrehaili AA, Albureikan MOI, Gharib AF, Daghistani H, Bakhuraysah MM, et al. In vitro studies on the pharmacological potential, anti-tumor, antimicrobial, and acetylcholinesterase inhibitory activity of marine-derived Bacillus velezensis AG6 exopolysaccharide. RSC Adv 2023;13(38):26406–17. CrossRef
54. Mahgoub AM, Mahmoud MG, Selim MS, Awady MEEL. Exopolysaccharide from marine Bacillus velezensis MHM3 induces apoptosis of human breast cancer MCF-7 cells through a mitochondrial pathway. Asian Pac J Cancer Prev 2018;19(7):1957.
55. Gomaa M, Yousef N. Optimization of production and intrinsic viscosity of an exopolysaccharide from a high yielding Virgibacillus salarius BM02: study of its potential antioxidant, emulsifying properties and application in the mixotrophic cultivation of Spirulina platensis. Int J Biol Macromol 2020;149:552–61. CrossRef
56. Gandhi HP, Ray RM, Patel RM. Exopolymer production by Bacillus species. Carbohydr Polym 1997;34(4):323–7. CrossRef
57. Hong T, Yin JY, Nie SP, Xie MY. Applications of infrared spectroscopy in polysaccharide structural analysis: progress, challenge and perspective. Food Chem: X 2021;12:100168. CrossRef
58. Tareb R, Bernardeau M, Amiel C, Vernoux JP. Usefulness of FTIR spectroscopy to distinguish rough and smooth variants of Lactobacillus farciminis CNCM-I-3699. FEMS Microbiol Lett 2017;364(2):fnw298. CrossRef
59. Li SW, Sheng GP, Cheng YY, Yu HQ. Redox properties of extracellular polymeric substances (EPS) from electroactive bacteria. Sci Rep 2016;6(1):39098. CrossRef
60. Schmid J, Sieber V, Rehm B. Bacterial exopolysaccharides: biosynthesis pathways and engineering strategies. Front Microbiol 2015;6:496. CrossRef
61. Ahmed Z, Wang Y, Anjum N, Ahmad A, Khan ST. Characterization of exopolysaccharide produced by Lactobacillus kefiranofaciens ZW3 isolated from Tibet kefir–Part II. Food Hydrocoll 2013;30(1):343–50. CrossRef
62. Schwehr KA, Xu C, Chiu MH, Zhang S, Sun L, Lin P, et al. Protein: polysaccharide ratio in exopolymeric substances controlling the surface tension of seawater in the presence or absence of surrogate Macondo oil with and without Corexit. Mar Chem 2018;206:84–92. CrossRef
63. Yang H, Wu D, Li H, Hu C. The extracellular polysaccharide determine the physico-chemical surface properties of Microcystis. Front Microbiol 2023;14:1285229. CrossRef
64. Huang X, Wang S, Fu L, Fang F. Characterization of extracellular polymeric substances by microscopic imaging techniques in wastewater biotreatment: a review. Environ Eng Sci 2022;39(6):493–585. CrossRef
65. Costa OYA, Raaijmakers JM, Kuramae EE. Microbial extracellular polymeric substances: ecological function and impact on soil aggregation. Front Microbiol 2018;9:1636. CrossRef
66. Zadeh HP, Fermoso FG, Collins G, Serrano A, Mills S, Abram F. Impacts of metal stress on extracellular microbial products, and potential for selective metal recovery. Ecotoxicol Environ Saf 2023;252:114604. CrossRef